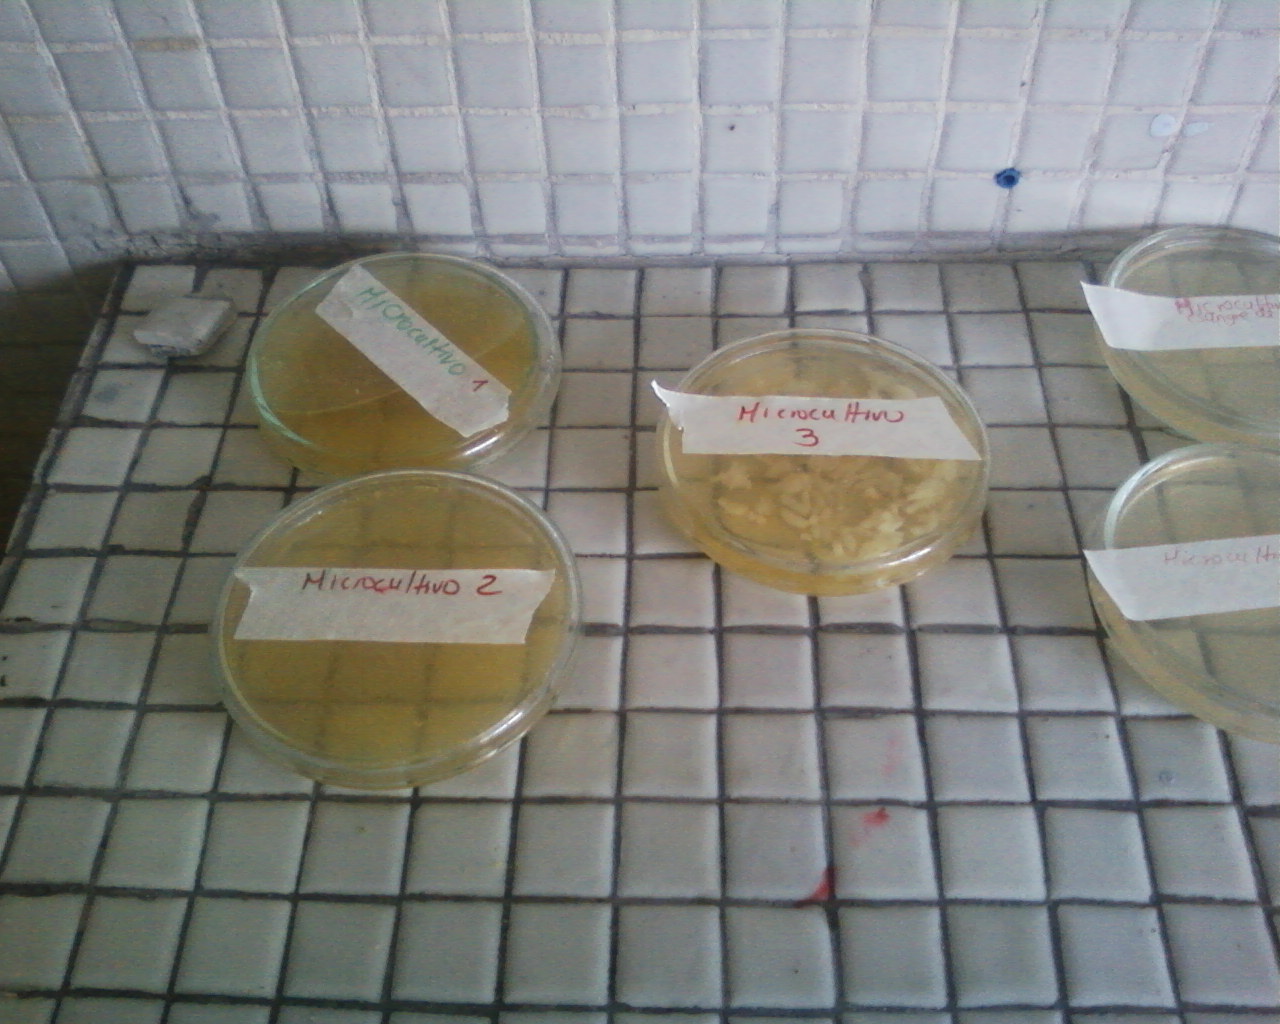

Los microorganismos
Este es nuestro proyecto de investigación para nuestra feria institucional, es contrucción de los niños como este habran muchos espacios donde los niños a través de sus preguntas investigativas generen aprendizajes, apoyemos a nuestros niños cientificos.Formato de Proyectos Feria de la CT+I 2011-1.doc (271 kB)